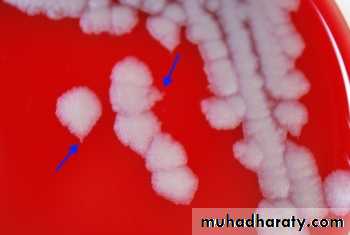
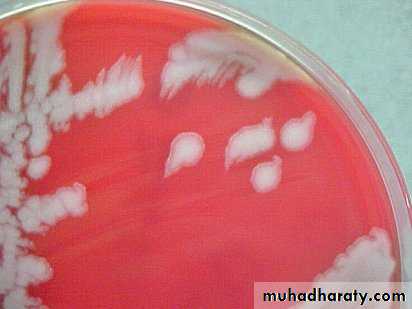

Gram Positive Bacilli Genus Bacillus Spore Forming
Genus Bacillus
Spore forming gram positive Bacilli: divided into two groups:Aerobic or facultative anaerobic bacteria Bacillus: Important species are:-
• Bacillus anthracis – Anthrax.
• Bacillus cereus – food poisoning.
• Bacillus stearothermophilus – efficiency testing of an autoclave.
Obligate anaerobic – Clostridia: Important species include:-
• Clostridium botulinum – botulism (food poisoning).
• Clostridium difficile – pseudomembranous colitis.
• Clostridium tetani – tetanus.
• Clostridium perfringens – gas gangrene.
Genus Bacillus
Features:
• Gram-positive, spore-forming rods that may form chains. Although spores survive for decades in dry environments, they quickly germinate in rich moist conditions and transform into metabolically active vegetative cells.
•
Bacillus anthracis – Anthrax.
Bacillus anthracis It is the causative agent of an important zoonotic disease called Anthrax. It also gained importance recently because of its ability to be used as Biological Weapon. So the Anthrax is primarily a disease of herbivores goats, sheep, cattle, horses.Anthrax is endemic among agrarian societies in developing countries in Africa, the Middle East, and Central America.
Bacillus anthracis – Anthrax.
Virulence Factors and Pathogenesis:
• Bacillus anthracis produces a unique capsule that is comprised of poly-D-glutamic acid and is anti phagocytic.
• Anthrax toxins are made up of three proteins
• Protective Antigen (PA),
• Edema Factor (EF),
• Lethal Factor (LF).
• Toxin synthesis is controlled by a plasmid (Gene pX01).
• Loss of plasmid makes the strain avirulent.
• This was probably the basis of original anthrax vaccine prepared by Pasteur.
EF
PA
LF
Bacillus anthracis – Anthrax.
Virulence Factors and Pathogenesis:• Protective Antigen (PA),
• PA is a protein that binds to specific cell receptors, and after proteolytic activation, it forms a membrane channel that mediates entry of EF and LF into the cell.
• Edema Factor (EF),
• EF is an adenylate cyclase; with PA, it forms a toxin known as edema toxin.
• Edema toxin is responsible for cell and tissue edema.
• Lethal Factor (LF).
• LF plus PA form lethal toxin, which is a major virulence factor and cause of
• death in infected animals and humans.
EF
PA
LF
Synergistically to Produce Damaging Effects
Bacillus anthracis – Anthrax.
Human Transmission, Human beings acquire infection by:• Cutaneous mode: By spores entering through the abraded skin; seen in people with occupational exposure to animals (most common mode),
• By inhalation of spores,
• Ingestion of carcasses of animals dying of anthrax containing spores (manifested as bloody diarrhea).
Types of human anthrax: Mainly three types:
• Cutaneous,
• Pulmonary and
• Intestinal anthrax
Bacillus anthracis – Anthrax.
Clinical Findings:In humans, approximately 95% of cases are cutaneous anthrax,
5% are inhalation,
Gastrointestinal anthrax is very rare.
Bacillus anthracis – Anthrax.
Clinical Findings:• Cutaneous anthrax:
• Occurs on exposed surfaces of the arms or hands followed in frequency by the face and neck. A pruritic papule develops 1–7 days after entry of the organisms or spores through a scratch. Initially, it resembles an insect bite.
• The papule rapidly changes into a vesicle or small ring of vesicles that coalesce, and a necrotic ulcer develops.
• The lesions typically are 1–3 cm in diameter and have a characteristic central black eschar.
•
Bacillus anthracis – Anthrax.
Clinical Findings:• Cutaneous anthrax:
• After 7–10 days, the eschar is fully developed. Eventually, it dries, loosens, and separates; healing is by granulation and leaves a scar.
• In as many as 20% of patients, cutaneous anthrax can lead to sepsis, the consequences of systemic infection including meningitis and death.
Bacillus anthracis – Anthrax.
Clinical Findings:• Pulmonary anthrax (wool sorter's disease):
• Caused by inhalation of spores, is characterized by progressive hemorrhagic lymphadenitis (inflammation of the lymph nodes).
• hemorrhagic mediastinitis (inflammation of the mediastinum),
• has a mortality rate approaching 100 percent if left untreated.
• The incubation period 6 weeks.
Bacillus anthracis – Anthrax.
Clinical Findings:• Gastrointestinal anthrax.
• Occurs when the spores are inoculated into a lesion on the intestinal mucosa after ingestion of the spores,
• The symptoms include:-
• abdominal pain, nausea, anorexia, and vomiting. Bloody diarrhea can also occur.
• Gastrointestinal anthrax accounts for less than 1% of the total cases worldwide
Bacillus anthracis – Anthrax.
Laboratory Diagnosis:• Is a large square-ended, gram-positive, found singly or in chains. (Gram staining: chain of bacilli arranged in bamboo stick appearance).
• Gram stain preparations of clinical samples.
• Encapsulated gram-positive rods in the blood is strongly presumptive for Bacillus anthracis identification.
• Cultures can be incubated in an atmosphere containing increased CO2.
• The spores are generally not present in clinical samples.
Bacillus anthracis – Anthrax.
Laboratory Diagnosis:• Cultural Characteristics:
• On sheep Blood Agar plate: Medusa head appearance colony (under low power microscope).
• Nonhemolytic colonies.
• Selective medium: PLET (polymyxin-lysozyme-EDTA-thallous acetate)
•
Bacillus anthracis – Anthrax.
Laboratory Diagnosis:• DFA (Direct fluorescent antibody test): Detects capsular antigen. It is used for confirmation of diagnosis during bioterrorism outbreaks.
• (PCR). These tests are available in most public health laboratories.
• A rapid enzyme-linked immunoassay (ELISA) that measures total antibody to PA has been approved by the U.S. Food and Drug Administration (FDA),
• Ascoli’s thermo precipitin test: It is a ring precipitation test, detects anthrax antigens.
•
Bacillus anthracis – Anthrax.
Treatment:• Cutaneous anthrax responds to Ciprofloxacin.
• In recommended for inhalation Anthrax. Multidrug therapy (for example, Ciprofloxacin plus Rifampin plus Vancomycin).
• In the setting of potential exposure to Bacillus anthracis as an agent of biologic warfare, prophylaxis with Ciprofloxacin or Doxycycline should be given for 60 days and
• Three doses of vaccine (AVA BioThrax) should be administered.
Bacillus anthracis – Anthrax.
Prevention:• In the United States, the current FDA-approved vaccine (AVA BioThrax®, Emergent BioSolutions, Inc, Rockville, MD).
• The dose schedule is 0.5 mL administered intramuscularly at 0 and 4 weeks and then at 6, 12, and 18 months followed by annual boosters.
• The vaccine is available only to the U.S. Department of Defense and to persons at risk for repeated exposure to B anthracis.
Bacillus anthracis – Anthrax.
Control measures:• disposal of animal carcasses by burning or by deep burial in lime pits,
• decontamination (usually by autoclaving) of animal products,
• protective clothing and gloves for handling potentially infected materials,
• active immunization of domestic animals with live attenuated vaccines.
The End
THANKSBacillus cereus – Food poisoning.
Bacillus cereus Is a relatively common cause of food poisoning and opportunistic infections in susceptible hosts. Food poisoning caused by B. cereus takes two forms: Diarrheal and Emetic.It is a normal inhabitant of soil, also widely isolated from food items, such as vegetables, milk, cereals, spices, meat and poultry.
Spores survive cooking and reheating.
Causes foodborne gastroenteritis – 2 patterns of disease (Diarrhoeal & Emetic); both types are mild & self limited, requiring no specific therapy.
Bacillus cereus is a major cause of enterotoxin food poisoning,
Food poisoning occurs after ingestion of preformed toxin,
The toxin is protein in nature and can be destroyed by heating,
Vomiting occurs 1-5 hours after ingestion
Bacillus cereus – Food poisoning.
Bacillus cereus is an important cause of eye infections, such as severe keratitis and endophthalmitis But rarely.
Bacillus cereus is a soil organism that commonly contaminates rice. When large amounts of rice are cooked and allowed to cool slowly, the B cereus spores germinate.
and the vegetative cells produce the toxin during log-phase growth or during sporulation.
Bacillus cereus – Food poisoning.
Bacillus cereus
clinical presentationGastroenteritis
Diarrhoeal Disease
Emetic form
Wide range of foods including cooked meat & vegetables Incubation period > 6 hours Diarrhoea & abdominal pain Lasts 20-36 hours
Chinese fried rice exclusively
Incubation period < 6 hours
Severe vomiting
Lasts 8-10 hours
Bacillus cereus – Food poisoning.
Bacillus cereus (Emetic type toxin):• Preformed toxin
• IP: 1–5 hours
• Heat stable
• MIC. food: Rice (Chinese fried rice)
• MIC. feature: Vomiting,
• abdominal cramps
• MIC. serotype: 1,3,5
Bacillus cereus – Food poisoning.
Laboratory diagnosis:Bacillus cereus can be grown aerobically at 37° C on SBA. A β-hemolytic frosted glass–appearing colony.
Selective media such as PEMBA(polymyxin B, egg yolk.
Bacillus cereus on sheep blood agar (SBA).
Bacillus cereus – Food poisoning.
Treatment:Bacillus cereus is susceptible to:-
Clindamycin, Erythromycin, Vancomycin.
It is resistant to Penicillin (by producing β-lactamase) and Trimethoprim.
Bacillus cereus – Food poisoning.
Bacillus cereusDiarrheal type
Emetic type
Incubation period
8–16 hours
1–5 hours
Toxin
Heat labile
Heat stable
Secreted in intestine (Similar to Clostridium perfringens enterotoxin)
Preformed toxin (formed in diet, similar to Staphylococcus aureus enterotoxin)
Food items contaminated
Meat, vegetables, dried beans, cereals
Rice (Chinese fried rice)
Clinical feature
Diarrhea, fever, rarely nausea
Vomiting, abdominal cramps